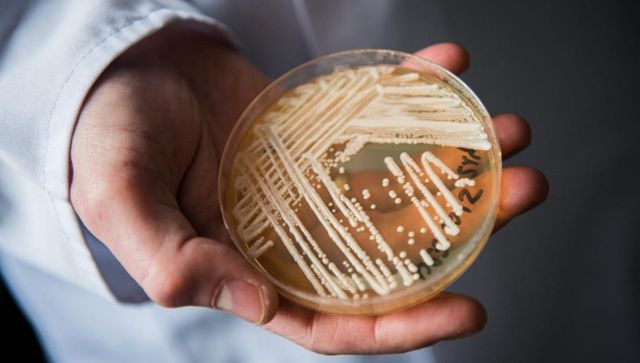
Explained: Candida auris, the deadly fungus spreading across the US Explained: Candida auris, the deadly fungus spreading across the US

A dangerous new fungus has now spread across half the United States.
The Centers for Disease Control and Prevention on Monday said the Candida auris is spreading at an ‘alarming rate’ and has described the fungus as an urgent antimicrobial resistance (AR) threat.
Let’s take a closer look:
What is it?
The fungus, Candida auris, is a form of yeast that is usually not harmful to healthy people but can be a deadly risk to fragile hospital and nursing home patients.
It spreads easily and can infect wounds, ears and the bloodstream.
The fungus can live on surfaces for several weeks, as per CDC.
It was first identified in Japan in 2009. It has since spread to more than 30 countries, as per NPR.
The World Health Organisation last year put Candida auris on its list of “fungal priority pathogens”, as per BBC.
The United States had its first case in 2013, but that was not reported till 2016. That year, US health officials reported 53 cases of Candida auris.
The new study found cases have continued to shoot up, rising to 476 in 2019, to 756 in 2020, and then to 1,471 in 2021.
In 2022, Candida auris infected at least 2,377 people, as per the Wall Street Journal.
Quick Reads
View AllAccording to the newspaper, Mississippi has had a dozen such cases since November.
“Unfortunately, multi-drug resistant organisms such as C. auris have become more prevalent among our highest risk individuals, such as residents in long-term care facilities,” Tammy Yates, spokesperson for Mississippi State Department of Health, told NBC News.
According to the CDC, between 30 and 60 per cent of infected have died from the yeast. However, the agency notes that statistic is “based on information from a limited number of patients.”
Many of the first US cases were infections that had been imported from abroad, but now most infections are spread within the US, the authors noted.
Some strains of the Candida auris are so-called superbugs that are resistant to all three classes of antibiotic drugs used to treat fungal infections.
As per USA Today, the most common symptom of a Candida auris are fever and chills that don’t get better after anti-biotics are administered.
“The scary thing about Candida auris and any of the drug-resistant fungal infections is just how difficult it is to find good, safe antifungals because people and fungi are built of the same stuff,” Lance B Price, professor of environmental and occupational health and the founder and co-director of the Antibiotic Resistance Action Center at George Washington University told USA Today.
Price added that the rise in cases and increase in drug-resistant strains could be caused by antifungals being overused in agriculture.
While it can be identified by testing bodily fluids, it is difficult to differentiate from other fungi – making misdiagnosis likely, as per CDC.
“Hospitals have to step up and screen patients for drug-resistant strains, isolate them, be on top of their game when it comes to infection control,” Price added.
COVID-19 likely drove spread, say experts
The COVID-19 pandemic likely drove part of the increase, researchers at the Centers for Disease Control and Prevention wrote in the paper published Monday by Annals of Internal Medicine.
Hospital workers were strained by coronavirus patients, and that likely shifted their focus away from disinfecting some other kinds of germs, they said.
Doctors have also detected the fungus on the skin of thousands of other patients, making them a transmission risk to others.
“The rapid rise and geographic spread of cases is concerning and emphasizes the need for continued surveillance, expanded lab capacity, quicker diagnostic tests, and adherence to proven infection prevention and control,” CDC epidemiologist Dr Meghan Lyman was quoted as saying by NPR.
With inputs from agencies
Read all the Latest News , Trending News , Cricket News , Bollywood News , India News and Entertainment News here. Follow us on Facebook , Twitter and Instagram .
)